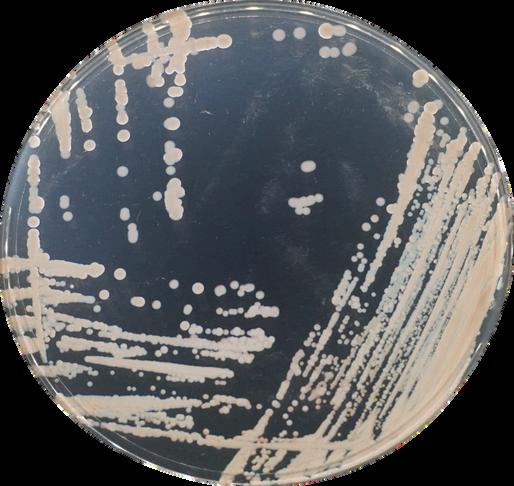

Catálogo de SERVIÇOS 2024

Sobre nós
O S2AQUAcoLAB é uma Associação sem fins lucrativos e de natureza privada, fundada em 2021, que se dedica à investigação e desenvolvimento experimental na área da aquacultura.
Esta organização é composta por uma equipa de investigadores própria e uma rede alargada, com mais de 50 investigadores associados, que conjuntamente cobrem diversas áreas incluindo otimização da produção, saúde e bem-estar, alterações climáticas, desenvolvimento de novos produtos e tecnologias, assim como formação.

A organização possui 16 associados institucionais e empresariais no setor da aquacultura.
A missão do S2AQUAcoLAB é responder às necessidades atuais da indústria, focando-se na promoção de uma aquacultura mais inteligente e sustentável, baseada no conhecimento científico, inovação e desenvolvimento tecnológico.





O nosso catálogo de serviços é um portfolio completo de soluções, pensadas à medida das necessidades da indústria, ajudar a indústria a crescer de forma diferenciadora.
Estamos prontos para arregaçar as mangas e trabalhar consigo nestes e noutros serviços especializados que pretenda, sob demanda.
O S2AQUAcoLAB é o seu parceiro estratégico na área da Aquacultura!


www.s2aquacolab.pt





ESTUDOS, PLANEAMENTO E OUTROS SERVIÇOS
FORMAÇÃO TÉCNICA ESPECIALIZADA 2

3 SAÚDE, BEM-ESTAR E BIOSSEGURANÇA DE ANIMAIS AQUÁTICOS


4 INTERAÇÕES AMBIENTAIS





MODELAÇÃO E TECNOLOGIAS EMERGENTES 8
LINHAS CELULARES PARA ENSAIOS IN VITRO
9 10 ORGANIZAÇÃO DE EVENTOS E COMUNICAÇÃO CIENTÍFICA

Estudo, Planeamento e Produção em Aquacultura
No S2AQUAcoLAB, desenvolvemos estudos de planeamento, caraterização de locais para a definição de layouts e modelos de produção. Oferecemos também assistência na elaboração de projetos de investimento e de infraestruturas. A nossa equipa fornece também apoio técnico, científico e de gestão e consultoria, na área de projetos de investigação, promovendo o crescimento, suportando a indústria, trazendo inovação e arrojo ao setor da Aquacultura.
Lista de serviços
Estudo e planeamento com vista à implementação de estruturas aquáticas (ex. tanques de terra, jaulas).
Consultadoria em zootecnia e produção. Planeamento de estruturas, mecanismos e ferramentas de monitorização e controlo ambiental e de produção. Construção de Planos higieno-sanitários no cultivo de organismos marinhos.
Gestão e acompanhamento de projetos na área da Aquacultura; Consultoria personalizada e especializada. Consultoria e gestão na área de projetos de investigação.
Aplicações
Propor diagnósticos e soluções zootécnicas com vista à melhor rentabilização da produção.
Promover o desenvolvimento de práticas e soluções inovadoras que beneficiem não só a indústria, mas também a sociedade e o meio ambiente.
Diminuir a incerteza e o risco de operações, ao promover o acompanhamento de projetos e infraestruturas, por parte de recursos qualificados e experientes.
Gerir projetos e garantir o seu bom cumprimento junto de entidades financiadoras.
02
Formação Técnica
Especializada
A área de formação especializada em Aquacultura é uma das principais áreas de atuação do S2AQUAcoLAB. Contando com recursos humanos altamente qualificados e muito experientes em Aquacultura, o S2AQUAcoLAB encara a transferência de conhecimento e a capacitação técnica como peças importantes da sua missão.
Lista de serviços
Programa de Formação Essencial para capacitação de recursos humanos com ferramentas essenciais para se integrarem com sucesso no setor da aquacultura (ex: Cursos de inglês à medida).
Programa de Formação Personalizado: capacitação dos recursos humanos do setor nas temáticas críticas à indústria, através do desenvolvimento de formação à medida. O S2AQUAcoLAB conta com uma equipa de recursos humanos altamente experientes e com grande prática na área da aquacultura, com experiência nas mais variadas áreas:
Apoio à produção de peixes marinhos
Apoio à produção de bivalves
Apoio à produção de macroalgas
Biotecnologia em Aquacultura

Patologia e sanidade em organismos marinhos
Gestão de reprodutores
Nutrição em Aquacultura
Aquacultura em terra e em mar aberto
Melhores práticas em aquacultura
Novas espécies e organismos ornamentais
Certificação em Aquacultura e biossegurança
Sistemas in-vitro na Aquacultura
Atualmente temos disponíveis na plataforma de aprendizagem
Moodle do S2AQUAcoLAB, três cursos que decorrem em formato assíncrono:
Sanidade e patologia em peixes marinhos
Cultivo larvar de peixes marinhos
RAS – Sistemas de recirculação em aquacultura
Programa de Formação em Inovação: Irá permitir que estudantes de unidades curriculares de curta duração, mestrados e doutoramento recebam formação de alta qualidade enquanto desenvolvem os seus projetos de investigação com os nossos parceiros (ambiente industrial) e melhoram as suas competências interpessoais.
Aplicações
Tornar o setor mais competitivo e capaz, através da formação de recursos humanos mais eficientes qualificados e capazes de responder aos desafios do setor.
Saúde, Bem-estar e Biossegurança de Animais Aquáticos
A equipa multidisciplinar do S2AQUAcoLAB, com especializações que abrangem as áreas de ecologia, patologia, microbiologia, biologia molecular e biologia funcional, oferece um conjunto de serviços que munem os produtores de ferramentas para resolução de problemas e suportam na implementação de boas práticas para a saúde, bem-estar e segurança dos organismos produzidos. Dessa forma, podem prevenir-se perdas na produção, preservar o valor de mercado e garantir a segurança e qualidade alimentar dos produtos.
Lista de serviços
Levantamentos dos procedimentos da produção.
Análise patológica de organismos marinhos.
Identificação bacteriana através de metodologias bioquímicas.
Deteção precoce de patógenos (bactérias, parasitas e vírus) utilizando técnicas de biologia molecular.
Ensaios challenge in vivo e in vitro para avaliação de estratégias de mitigação.
Análise de parâmetros bioquímicos, de osmorregulação e hematologia.
Análise de parâmetros de imunologia, stress geral e oxidativo através de análises bioquímicas e de expressão genética.
Deteção, identificação e quantificação de biotoxinas marinhas, em ecossistemas aquáticos.
Testagem de bioacumulação e efeitos fisiológicos em organismos expostos a compostos químicos.
Análise de malformações ósseas em peixes nos estádios de desenvolvimento larvar e juvenil.
Lista de serviços de deteção disponíveis
Bactérias: Vibrios, Photobacterium damselae, Tenacibaculum,
Aeromonas, Pseudomonas, Clamídia.
Parasitas: Amyloodinium, Amebas, Monogenea, Mixo e Microsporídios
Vírus: Nodavírus e Norovírus.
Entre outros...
Aplicações
Minimizar a incidência de doenças e infeções para prevenir perdas na produção.
Assegurar um diagnóstico precoce de forma a aumentar a eficácia de estratégias de mitigação.
Garantir a qualidade e segurança alimentar dos produtos distribuídos no mercado.
Selecionar larvas e juvenis saudáveis para garantir a aquisição de lotes com maior qualidade.
Promover melhores práticas de cultivo e de bem estar animal.
04
Interações Ambientais
O S2AQUAcoLAB oferece soluções para compreender e prever parâmetros ambientais, essenciais na seleção da localização/área mais adequada para a implementação de explorações aquáticas costeiras e offshore. Avaliamos também o impacto das explorações no ambiente circundante, para garantir que a produção ocorra de forma responsável e sustentável.
Lista de serviços
Monitorização de temperatura, salinidade, oxigénio dissolvido e turbidez em ambientes aquáticos.
Análise de abundância e diversidade de espécies de micro- e macroplâncton em ambiente marinho. Análise de nutrientes dissolvidos na água (amónia, nitritos, nitratos, azoto total, e fosfatos).
Análise de carbono e azoto em amostras de água e sedimento.
Análise local/regional de dados de temperatura da superfície do oceano e clorofila.
Análise local/regional de dados hidrodinâmicos e meteorológicos (p.e. correntes, ondas, vento).
Previsão de parâmetros climáticos, relevantes ao planeamento a longo prazo de explorações aquáticas.
Aplicações
Contribuir para estudos de impacto ambiental.
Avaliar processos de biorremediação em Aquacultura Multi-Trófica Integrada (IMTA).
Auxiliar na seleção do local ideal para iniciar explorações em águas costeiras e mar aberto.
Contribuir para a identificação de necessidades e planeamento de explorações aquáticas.
Reprodução
No S2AQUAcoLAB, consideramos que os peixes reprodutores são uma base essencial na Aquacultura. Uma seleção cuidadosa assegura a saúde e a sustentabilidade dos sistemas, contribuindo para o sucesso da produção. Oferecemos soluções para melhorar a reprodução de stocks de espécies marinhas, aumentando a qualidade e quantidade de sémen, ovos e larvas para impulsionar a produção. Investigamos os fatores que afetam o sucesso reprodutivo de espécies marinhas, adaptando os nossos serviços às necessidades do cliente.
Lista de serviços
Avaliação da qualidade dos gâmetas. Procedimentos de armazenamento de sémen.
Análise do nível de hormonas esteróides no sangue. Consultadoria para desenvolvimento de protocolos de reprodução.
Aplicações
Sincronizar ciclos reprodutivos para melhor controlo da produção dentro e fora de época.
Disponibilizar sémen para programas de seleção genética.
Aumentar a quantidade e qualidade de sémen e ovos para impulsionar o sucesso reprodutivo.
Nutrição
No S2AQUAcoLAB, contribuímos para o desenvolvimento e teste de novas dietas e ingredientes alternativos, procurando aprofundar o conhecimento dos requisitos nutricionais de várias espécies de interesse para a Aquacultura. Dedicamo-nos também à otimização de planos de alimentação de forma a minimizar desperdícios, maximizar taxas de crescimento e assegurar a qualidade da água onde os organismos são cultivados.
Lista de serviços
Desenho, implementação e análise de dados em ensaios in vivo (p.e. crescimento, digestibilidade) com espécies relevantes para aquacultura e organismos modelo (p.e. peixe zebra).
Testagem de novos ingredientes e novas formulações de dietas. Seleção de compostos bioativos para utilização em aquacultura. Análises de composição proximal (humidade, cinzas, proteína, gordura bruta/total, fibra, energia).
Análise da atividade de enzimas digestivas (tripsina, amilase, lipase), stress oxidativo (SOD, catálase, glutationa) e parâmetros metabólicos (GDH).
Avaliação do estado intestinal (calprotectina, mucinas)
Ensaios de expressão genética para testar a eficácia de diferentes dietas.
Aplicações
Melhorar aspetos nutricionais relacionados com o crescimento, performance reprodutiva, resposta imunitária e bem-estar.
Desenvolver novos produtos alimentares.
Avaliar o valor nutricional de novas matérias-primas sustentáveis.
Avaliar perdas de macronutrientes das dietas libertados para o meio ambiente.
Produção de micro e macroalgas
O cultivo de macroalgas é uma área em expansão, permitindo a produção de biomassa com diversas aplicações comerciais, incluindo a integração em sistemas de Aquacultura Multi-Trófica Integrada (IMTA), que poderão ajudar o setornuma perspetiva de aquacultura sustentável economia circular. O S2AQUAcoLAB está comprometido em impulsionar este desenvolvimento através da realização de ensaios de cultivo de macroalgas e estudos de biorremediação.
Lista de serviços
Desenvolver e otimizar protocolos de cultivo de macroalgas em maternidade.
Ensaios de cultivo de macroalgas em micro e mesocosmos. Ensaios de cultivo de macroalgas.
Avaliação do potencial de biorremediação de azoto pelas macroalgas em sistemas de IMTA.
Estudos de cinética de absorção de azoto inorgânico por macroalgas.
Aplicações
Cultivo de macroalgas em maternidade, para subsequente cultivo em ambientes terrestres ou marinhos.
Potenciar o cultivo de novas espécies de macroalgas.
Fomentar a implementação de sistemas comerciais de IMTA.
Linhas Celulares para Ensaios
in vitro
Os sistemas celulares in vitro representam uma alternativa e um complemento aos ensaios in vivo, possibilitando a redução do número de animais em experimentação, de acordo com os princípios dos "3 R's", enquanto aceleram a obtenção de resultados. A sua aplicação contribui para a otimização de recursos, resultando na diminuição dos custos associados aos ensaios em aquacultura. No S2AQUAcoLAB, dispomos de diversas culturas primárias e linhas celulares derivadas de espécies economicamente relevantes para o setor, que permitem a realização de ensaios para vários fins.
Lista de serviços
Avaliação e impacto ao nível celular da citotoxicidade de contaminantes (xenobióticos, toxinas, micotoxinas) e infeção por patógenos e estudo dos mecanismos moleculares subjacentes. Avaliação dos requisitos nutricionais (p.e. vitaminas, minerais, ácidos gordos) para várias espécies.
Seleção de compostos bioativos que promovam a imunidade, crescimento e bem-estar animal.
Estabelecimento de novas linhas celulares sob demanda para ensaios em aquacultura tradicional e em aquacultura celular (produção de proteína em laboratório).
Aplicações
Avaliar o impacto de contaminantes presentes nos sistemas de produção de peixes
Desenvolver estratégias de mitigação para prevenir os efeitos adversos associados à toxicidade de contaminantes e novas terapias e alvos para prevenção de surtos de doença
Incorporar ingredientes funcionais em dietas para promover o bem-estar animal, estimular o crescimento e aumentar a resistência a doenças.
Modelação e Tecnologias Emergentes
O estabelecimento de bases de dados eficazes, acessíveis e baseadas em modelos reais é fundamental para o desenvolvimento de modelação inteligente e tecnologias cada vez mais eficientes no controlo e monitorização da produção em Aquacultura. O
S2AQUAcoLAB oferece uma gama de serviços na área da modelação e tecnologia, possibilitando aos produtores antecipar taxas de crescimento, prever cenários ambientais e identificar possíveis fontes de contaminação, de forma a evitar perdas económicas significativas.
Lista de serviços
Implementação de sistemas de monitorização e recolha de dados. Simulação de crescimento de peixes em diferentes cenários.
Identificação dos parâmetros mais relevantes ao crescimento.
Previsão local/regional de parâmetros oceânicos e meteorológicos relevantes à atividade.
Previsão probabilística de trajetórias de doenças infeciosas.
Cálculo do risco de contaminação cruzada.
Aplicações
Estabelecer base de dados a partir de dados recolhidos in loco.
Apoiar na gestão de atividades diárias da exploração e planeamento a curto-prazo.
Avaliar o potencial de negócios.
Avaliar o potencial da contaminação cruzada de doenças infeciosas em aquaculturas costeiras e em mar aberto.
Organização de Eventos e Comunicação
científica
A ciência e as soluções técnicas que propomos para o setor da Aquacultura representam uma melhoria significativa para o setor. A divulgação da investigação e da inovação são, cada vez mais, fundamentais, tanto junto de pares quanto do público em geral. Com uma vasta experiência nesta área, o S2AQUAcoLAB possui recursos e capacidade logística para a organização integral de eventos científicos, uma ferramenta bastante útil para divulgar conhecimento e promover a comunicação de ciência.
Lista de serviços
Organização de encontros científicos e preparação de toda a logística inerente.
Organização de eventos de disseminação científica em Aquacultura.
Desenvolvimento de planos de comunicação numa vertente multicanal.
Aplicações
Promover uma eficiente disseminação de resultados científicos junto de pares e do público em geral.
Divulgar ativamente a Aquacultura para promoção e transformação mercado.
Promover a comunicação de ciência junto de vários públicos.

Deteção de patógenos por PCR

DE BIOLOGIA MOLECULAR
Bactéria isolada (placa ou meio líquido)
Bactéria isolada + Sequenciação
Diretamente em tecido
Diretamente em tecido + Sequenciação
Deteção e quantificação de patógenos por qPCR
Nodavírus -VNN (4 genótipos/reação)
Norovírus (GI)
Norovírus (GII)
Análise de virulência
P. damselae
V. anguillarum
V. harveyi
T. maritimum
Ensaios de expressão genética:
1 Painel de 5 genes
2 Painéis de 5 genes
(Painéis disponíveis: crescimento e metabolismo, stress, imunidade, inflamação
Em desenvolvimento: metabolismo de lípidos, metabolismo do osso;
Espécies disponíveis: Dourada, Robalo e Corvina
Em desenvolvimento: Linguado, Pregado e Sardinha).
www.s2aquacolab.pt

Análise patológica básica a peixes marinhos
(parasitas externos e microbiológica)
Análise patológica a peixes marinhos
Parasitas externos
Parasitas internos
Microbiológica
Análise microbiológica Água
Ovos/Larvas
Antibiograma
Identificação bacteriana (bioquímica)
Análise histológica
Realização de ensaios de challenge com patógenos
Receitas veterinárias

Valor sob consulta
Valor sob consulta
www.s2aquacolab.pt


Análise da composição proximal
Homogeneização de Carcaça
Secagem e moagem de amostras
Humidade
Cinzas totais
Proteína Bruta (F=6,25)
Gordura Bruta
Gordura Total (hidrólise ácida)
Energia Bruta
Análise de deformações ósseas
3 tratamentos
Triplicados n=25
Análises bioquímicas
Stress
Parâmetros hematológicos
Parâmetros imunes

7.4€ 5.2€ 3.2€ 4.6€ 12.9€ 13.7€ 20.6€ 12.5€ 3994.5€
Valor sob consulta



Ensaios com Animais Marinhos (dourada, robalo, ostra, ameijôa, entre outros ...)
Ensaios in vivo
Ensaios com larvas
Ensaios pós larvas e juvenis
Ensaios de stress
Ensaios in vitro
8100€
Valor sob consulta
Valor sob consulta
2290€
Ensaios in vitro para avaliar a capacidade proliferativa e tempo de duplicação em linhas celulares de peixes
Outros
Consultadoria
Organização de eventos
60€/h
Valor sob consulta





